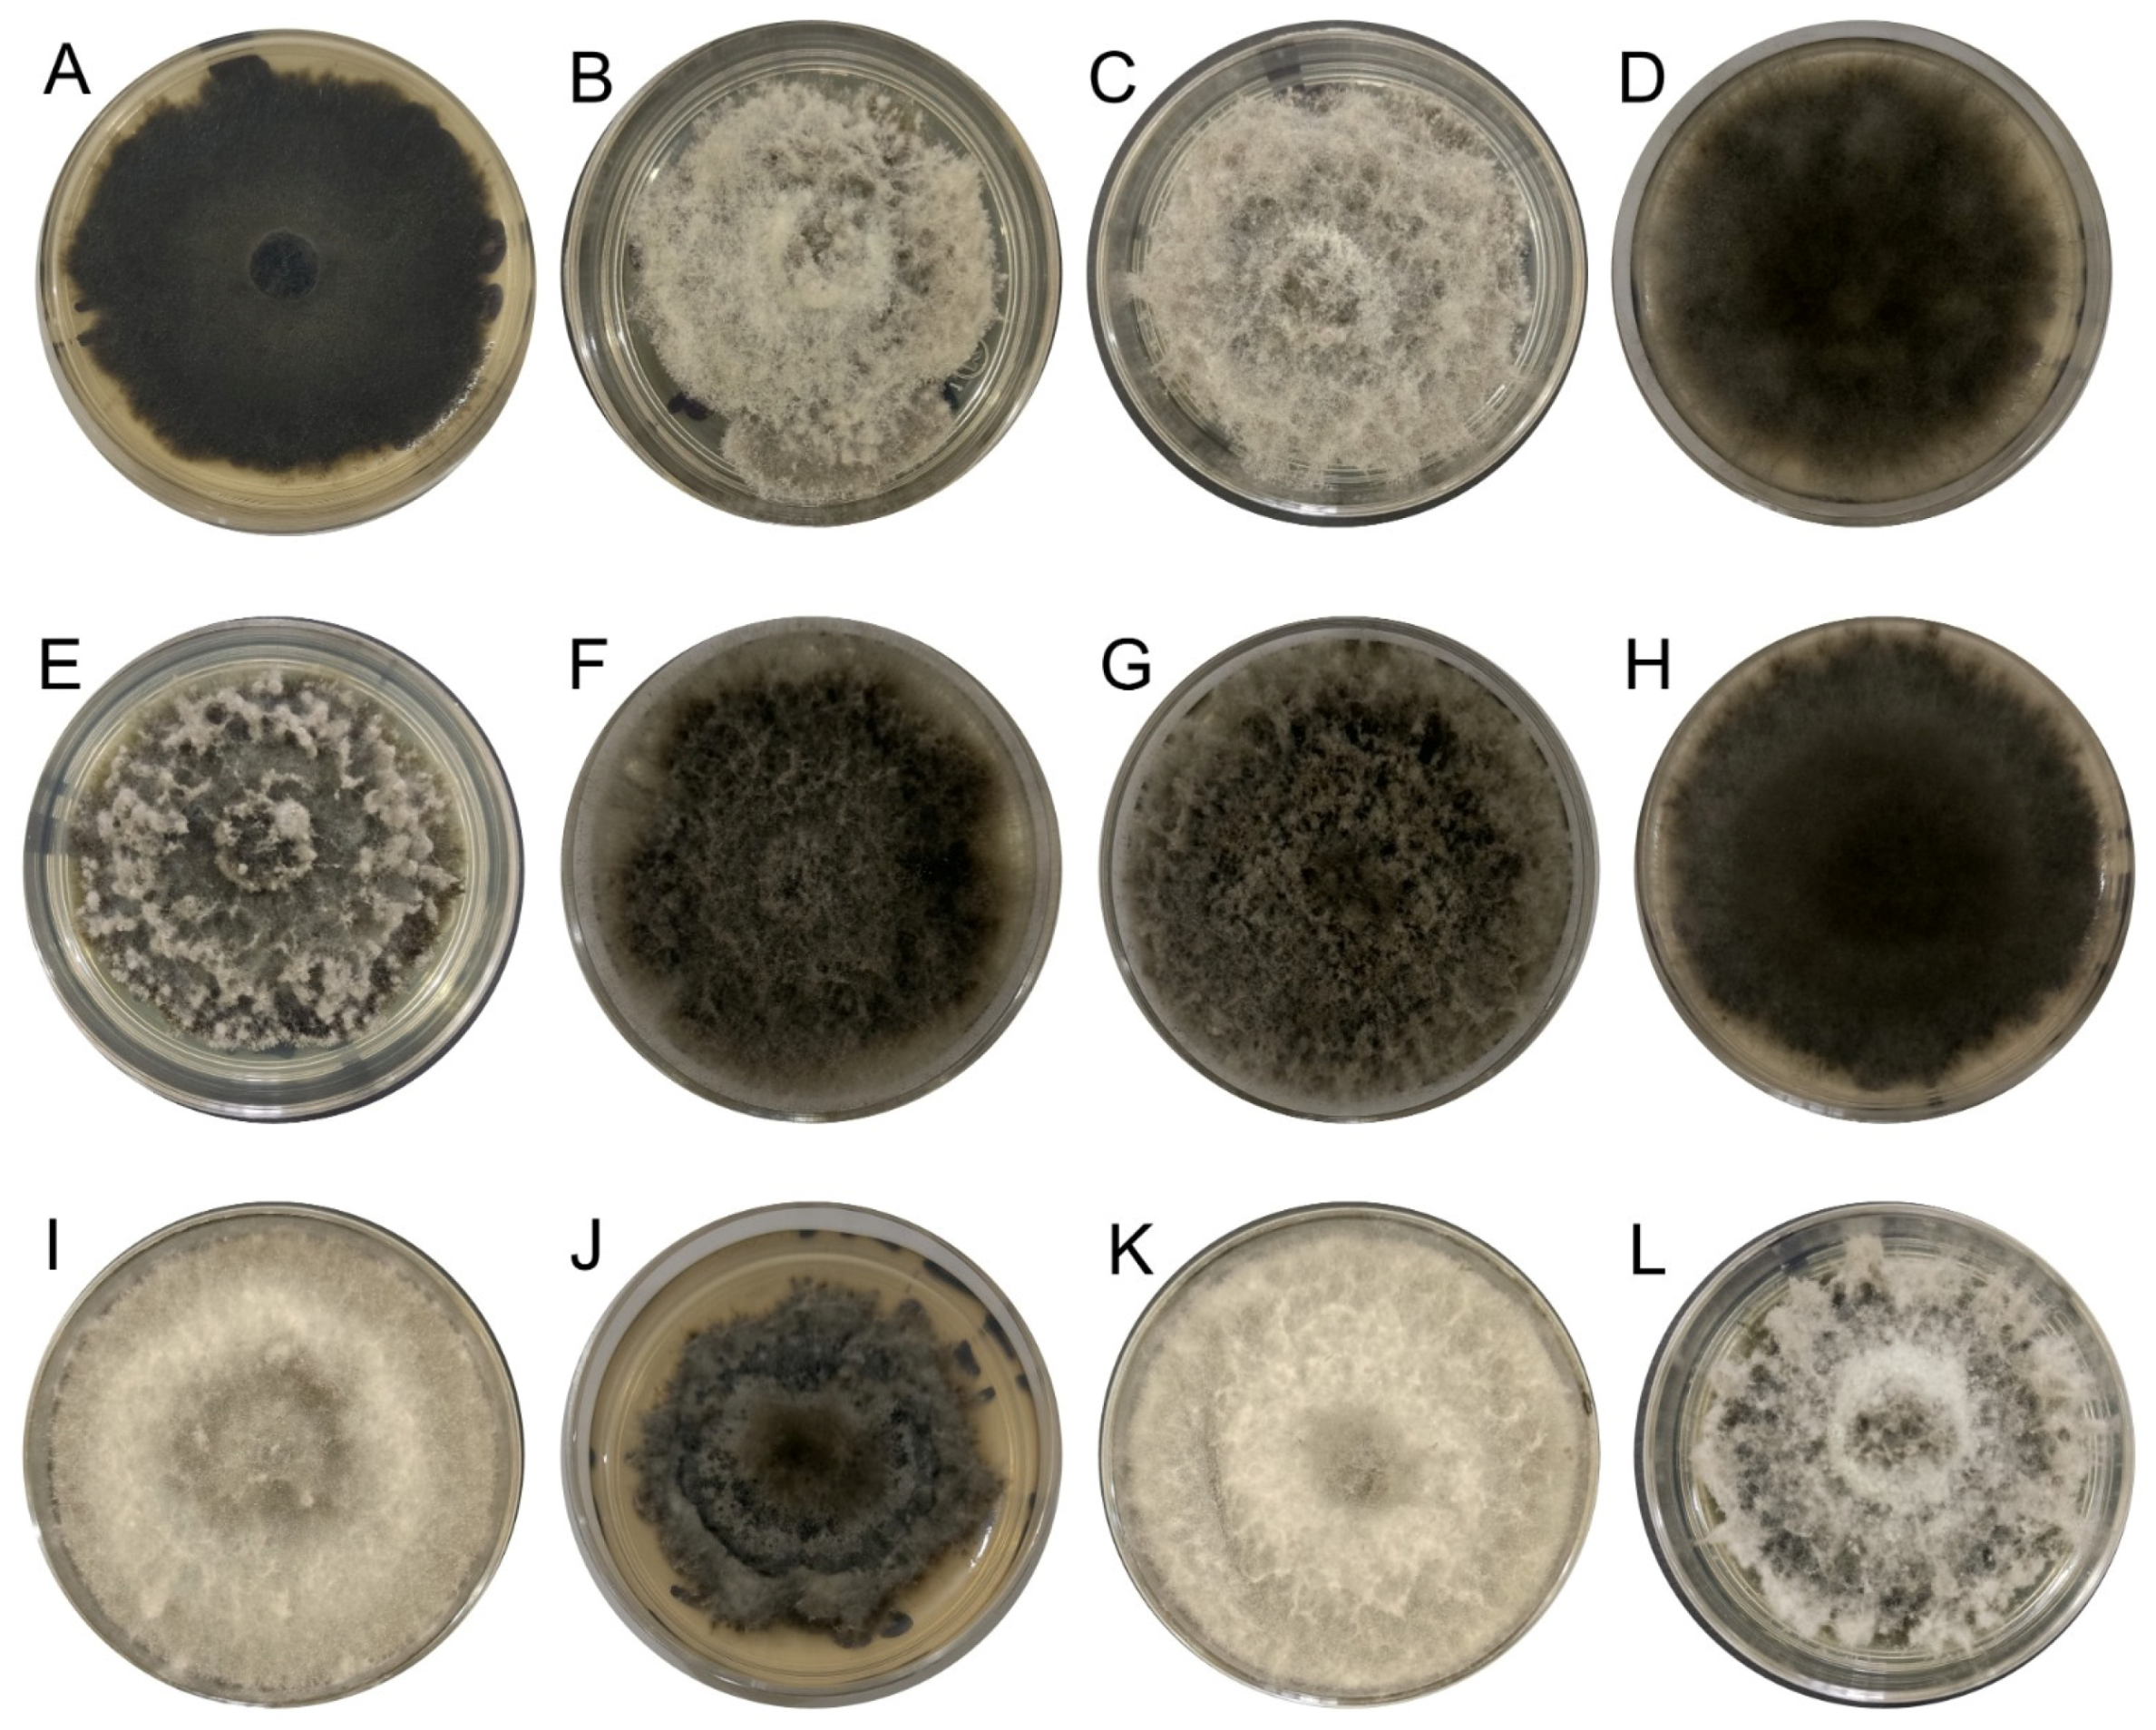
Jof 10 00484 g002

Abstract
Mexico ranks second in the world for Persian lime (Citrus latifolia) exports, making it the principal citrus exporter within the national citrus industry, exporting over 600,000 tons per year. However, diseases are the main factor reducing production, resulting in significant economic losses. Among these diseases, fungal diseases like dieback, caused by species of Lasiodiplodia, are an emerging issue in Persian lime. Symptoms include gummosis, twig and branch dieback, cankers, the necrosis of bark and wood, fruit mummification, and tree decline. The aim of this study was to investigate the occurrence and pathogenicity of the fungal species associated with twig and branch dieback, cankers, and decline of Persian lime trees in southern Mexico, and to elucidate the current status of the Lasiodiplodia species causing the disease in Mexico. During June, July, and August of 2023, a total of the 9229 Persian lime trees were inspected across 230 hectares of Persian lime orchards in southern Mexico, and symptoms of the disease were detected in 48.78% of the trees. Branches from 30 of these Persian lime trees were collected. Fungal isolates were obtained, resulting in a collection of 40 strains. The isolates were characterized molecularly and phylogenetically through the partial regions of four loci: the internal transcribed spacer region (ITS), the β-tubulin gene (tub2), the translation elongation factor 1-alpha gene (tef1-α), and the DNA-directed RNA polymerase II second largest subunit (rpb2). Additionally, pathogenicity was assessed, successfully completing Koch’s postulates on both detached Persian lime branches and certified 18-month-old Persian lime plants. Through multilocus molecular phylogenetic identification, pathogenicity, and virulence tests, five species were identified as causal agents: L. iraniensis, L. lignicola, L. mexicanensis, L. pseudotheobromae, and L. theobromae. This study demonstrates that in southern Mexico, at least five species of the genus Lasiodiplodia are responsible for dieback in Persian lime. Additionally, this is the first report of L. lignicola and L. mexicanensis as causal agents of the disease in citrus, indicating novel host interactions between species of Lasiodiplodia and C. latifolia.
1. Introduction
Globally, citriculture is regarded the most important agricultural endeavor within fruit production, yielding over 150 million tons annually. Citrus fruits are cultivated on all five continents, with Asia contributing 51.89%, the Americas 29.39%, Africa 11.44%, Europe 6.88%, and Oceania 0.39% of the global production [1]. The leading producing nations are China, Brazil, India, Mexico, and the United States.
Mexico ranks as the fourth largest citrus producer worldwide, cultivating a total of 852,717 hectares of various Citrus species. These include sweet orange (C. sinensis), Persian lime (C. latifolia), key lime (C. aurantifolia), tangerine (C. reticulata), and grapefruit (C. paradisi), with a production exceeding 8.9 million tons, representing a production value over USD 3 billion [1,2]. Regarding Persian lime, Mexico produces over 1.5 million tons, with a production value exceeding USD 650 million. Mexico ranks second globally in export, with more than 600 thousand tons, mainly to North American, European, and Asian markets, being the primary supplier to the United States of America [1,2].
However, one of the principal factors limiting citrus production is disease caused by fungal pathogens. Notable among these diseases are anthracnose caused by the Colletotrichum gloeosporioides species complex [3], gummosis caused by Phytophthora spp. [4], dieback, and decline caused by species of the Botryosphaeriaceae family [5,6]. These microorganisms cause symptoms such as chlorosis, reduced growth and development, deficiencies in water and nutrient absorption, rot, necrosis, gummosis, cankers, branch dieback, and plant death, in some cases [6,7].
Members of the Botryosphaeriaceae family cause trunk and branch diseases, leading to significant production losses [8]. Lasiodiplodia is one of the most phytopathologically important genera within this family, currently comprising 48 species widely distributed around the world and found on a broad spectrum of hosts, including monocotyledonous, dicotyledonous, and gymnospermous plants [5,9,10,11]. Most Lasiodiplodia species are known as pathogens, causing various plant diseases like stem cankers, gummosis on stems and branches, shoot blight, and fruit rot [9,11,12,13]. Furthermore, they are frequently observed as endophytes and saprobes. Under abiotic stress conditions, they thrive in subtropical and tropical regions, affecting more than 1000 hosts [14,15,16].
Due to the similarity in the cultural and morphological characteristics of species of the Botryosphaeriaceae, molecular and phylogenetic characterizations are essential for distinguishing the species [17,18]. Zhang et al. (2021) [10] found that species of the genera Botryosphaeria, Diplodia, Dothiorella, and Pseudofusicoccum can be phylogenetically separated using ITS, tef1-α, and tub2, while species of the genera Lasiodiplodia, Neofusicoccum, Neoscytalidium, Phaeobotryon, and Saccharata require ITS, LSU, tef1-α, tub2, and rpb2. However, it was recently determined that for accurate identification of Lasiodiplodia species, the combination of four loci—ITS, tef1-α, tub2, and rpb2—is necessary for reliable resolution, which was established among the possible multilocus combinations with SSU, LSU, ITS, tef1-α, tub2, and rpb2 [15].
Lasiodiplodia species are the primary etiological agents of citrus dieback and have been reported in various countries worldwide. For example, in Algeria, L. mediterranea and L. mitidjana were reported as the etiological agents of dead shoots, defoliation, cankers, wood necrosis, and dieback in C. sinensis [19]; in Brazil, L. caatinguensis and L. theobromae have been associated with gummosis and dieback [20,21]; in China, a study on seven citrus species (C. grandis, C. limon, C. maxima, C. paradisi, C. reticulata, C. sinensis, and C. unshiu) found that L. citricola, L. guilinensis, L. huangyanensis, L. iraniensis, L. linhaiensis, L. microconidia, L. ponkanicola, L. pseudotheobromae, and L. theobromae are associated with diseased tissues from twigs, branches, and trunks showing symptoms including cankers, cracking, dieback, and gummosis. All Lasiodiplodia species were pathogenic to Citrus reticulata shoots inoculated in vitro [22]. In Egypt, L. laeliocattleyae, L. pseudotheobromae, and L. theobromae were reported from the symptomatic branches of C. reticulata and C. sinensis exhibiting dieback. Pathogenicity test results showed that all Lasiodiplodia species were pathogenic [11]. In Iran, L. citricola, L. gilanensis, L. iraniensis, L. pseudotheobromae, and L. theobromae have been identified in citrus branches (Citrus sp. and C. aurantifolia) as causing cankers and dieback symptoms [23,24]; in Mexico, L. theobromae was reported to cause dieback of C. sinensis [25]. In Oman, the causal agents of dieback and gummosis in C. aurantifolia, and C. sinensis were L. hormozganensis, and L. theobromae; in C. reticulata, it was L. iraniensis [26]; and, in the United States of America, L. iraniensis, and L. parva have been reported as causing gummosis and dieback in C. sinensis, and Citrus sp., respectively [13,27].
Worldwide, the studies on dieback caused by Lasiodiplodia in citrus have not focused on Persian lime. Only one study in Mexico found that the disease agents were L. brasiliense, L. citricola, L. pseudotheobromae, L. subglobosa, and L. theobromae [28]. However, this study used only the ITS, tef-1α, and tub2 regions. Currently, for species of the genus Lasiodiplodia, the use of ITS, tef-1α, tub2, and rpb2 results in a more reliable species-level resolution [10,15]. Therefore, some identification errors of the species reported for Persian lime might have occurred.
In the past five years, dieback of Persian lime caused by Lasiodiplodia has not been studied. Therefore, it is important to understand the current status of Lasiodiplodia species causing dieback in Persian lime. Moreover, in southern Mexico, specifically in the state of Tabasco, the etiological agents have not been determined; this state contributes over 87 thousand tons to Persian lime production [2]. The objectives of this study were to (i) identify Lasiodiplodia species associated with dieback of Persian lime in southern Mexico, (ii) compare the previously described species associated with dieback in Persian lime with the current state of the species in the region, using the four recommended molecular markers, and (iii) evaluate their pathogenicity and virulence in excised green shoots and certified nursery plants of Persian lime.
2. Materials and Methods
2.1. Field Survey and Sampling
During June, July, and August of 2023, a survey was conducted of 230 hectares of Persian lime in the main producing region of Tabasco, Mexico. A total of thirty symptomatic plant tissues showing canker, gummosis, and branch dieback were collected (Figure 1), utilizing a completely random sampling method for symptomatic trees. The plant tissue was stored in marked plastic bags and placed in a plastic container with ice for transport to the laboratory.
Figure 1.
Symptoms caused by Lasiodiplodia spp. on Citrus latifolia (Persian lime) in southern Mexico. (A) Tree showing defoliation and tree decline. (B) Tree exhibiting dieback of twigs and branches. (C) Sunken canker on branch. (D) Twig dieback. (E) Branch dieback. (F) Fruit mummification.
2.2. Fungal Isolations from Persian Lime Branches with Dieback
Fungal isolates were obtained following standard protocol [28]. Fragments of approximately 3 cm from each branch were cut from the margin between the necrotic and healthy tissue zones. These were placed into a 50 mL conical tube containing 20 mL of water plus 5% commercial powdered detergent for 10 min to remove dirt and insects, then immersed in 0.6% sodium hypochlorite for 1 min, rinsed three times with sterile water, and blotted dried on sterile paper. Five pieces of wood (approximately 5 mm2 each) were placed into 100-by-15 mm Petri dishes containing potato dextrose agar (PDA; Difco, Detroit, MI, USA, 49 g L−1) supplemented with 0.5 g L−1 streptomycin sulfate and 0.4 g L−1 penicillin (Sigma-Aldrich Co., St. Louis, MO, USA). Plates were incubated at 25 °C for 48 h in the dark.
Selected emerging fungal colonies were transferred to Petri dishes containing 2% water agar, incubated in the dark for 48 h, and purified by transferring hyphal tips to Petri dishes containing PDA and incubated at 25 °C in the dark. The isolates used in this study were stored at −80 °C in 15% glycerol and deposited in the Culture Collection of Phytopathogenic Fungi of the Phytosanitary Diagnosis Laboratory of the Ixtacuaco Experimental Field of the National Institute of Forestry, Agricultural, and Livestock Research (INIFAP), where they are available upon request (https://www.gob.mx/inifap, accessed on 1 July 2024).
2.3. DNA Extraction, Polymerase Chain Reaction Amplification, and Sequencing
Isolates were cultured on PDA and incubated at 25 °C for 7 days. Aerial mycelium was directly collected from the medium using a sterile scalpel blade and transferred into 2 mL microtubes. Total genomic DNA was extracted using the cetyl trimethylammonium bromide (CTAB) method with slight modifications [29]. DNA concentrations were quantified using a NanoDrop OneC (Thermo Fisher Scientific, Madison, WI, USA), the DNA samples were diluted to a concentration of 100 ng/µL.
Partial regions of four loci, the internal transcribed spacer region (ITS), the β-tubulin gene (tub2), the translation elongation factor 1-alpha gene (tef1-α), and the DNA-directed RNA polymerase II second largest subunit (rpb2) were amplified using specific primer sets (Table 1).
Table 1.
Sequences of primers used in the identification of Lasiodiplodia strains.
All amplification reactions were performed in a total 25 μL volume mixture consisting of 12.5 μL of BlasTaq 2X PCR MasterMix (Applied Biological Materials, Vancouver, BC, Canada), 9.5 μL of Water Molecular Biology, 1 μL of each forward and reverse primer at a concentration of 10 μM, and 1 μL of 100 ng/μL DNA template. The amplification conditions comprised an initial denaturation step at 95 °C for 3 min, followed by 35 cycles of denaturation at 95 °C for 15 s, annealing at 55 °C for ITS region, 58 °C for tef1-α gene, and 60 °C for tub2 and rpb2 genes for 15 s, and extension at 72 °C for 10 s, followed by a final extension at 72 °C for 5 min. The PCR assays were conducted in a MiniAmp plus thermocycler (Thermo Fisher Scientific, Madison, WI, USA). The PCR products were separated by electrophoresis in a 1.5% agarose gel at 60 V for 90 min stained with ethidium bromide. The amplified PCR products were purified using Wizard SV Gel and PCR Clean-Up System (Promega, Madison, WI, USA) and sequenced in both directions by LANBAMA Laboratory (IPICYT, SLP, San Luis Potosi, Mexico), using the Sanger method.
2.4. Phylogenetic Analyses
Forward and reverse sequences were assembled using the Staden Package [34]. Sequences of each of the ITS, tef1-α, tub2, and rpb2 loci from 36 well-documented extype Lasiodiplodia species from culture [15] were retrieved from GenBank and aligned with sequences of the isolates obtained in this study (Table 2) using the MAFFT v.7 sequence alignment program [35]. The alignments were then manually checked and edited using MEGA XI [36]. Subsequently, the alignment of each locus was loaded into SequenceMatrix v.1.8 [37] to construct the concatenated matrix.
Table 2.
Culture accession numbers, host, location, and GenBank accession numbers of Lasiodiplodia isolates used in the phylogenetic analysis.
The phylogenetic trees for each locus (ITS, tef1-α, tub2, and rpb2) and for the concatenated matrix were inferred using both maximum likelihood (ML) and Bayesian inference (BI) criteria. ModelTest-NG v.0.1.7 [38] was employed to select evolutionary models independently for each locus and for all loci under the Akaike information criterion (AIC) in both BI and ML analyses.
ML analyses were performed using RAxML-HPC2 [39], with nonparametric bootstrap iterations run for 1000 replications employing the GTR+G+I substitution model. BI was conducted using MrBayes on XSEDE (v.3.2.7a) [40], implemented on the CIPRES Science Gateway portal (www.phylo.org, accessed on 1 July 2024) [41]. The BI trees were constructed utilizing the Markov chain Monte Carlo (MCMC) algorithm with four runs and four chains per run, running 10,000,000 generations. Trees and parameter values were sampled every 1000 generations, resulting in 10,000 trees. The initial 2500 trees were discarded as the burn-in phase, and the remaining 7500 trees were used to calculate the posterior probabilities (PPs) in the majority rule consensus tree. Tree topologies were visualized using the FigTree v1.4.0 program [42]. Sequences generated in this study were deposited in GenBank (Table 2), and the alignments and trees are available from TreeBASE (http://purl.org/phylo/treebase/phylows/study/TB2:S31354, accessed on 1 July 2024).
2.5. Pathogenicity Tests on Detached Branches of Persian Lime
The pathogenicity of the fungal strains was evaluated based on their ability to induce necrosis and gummosis in detached shoots collected from symptomless C. latifolia trees, following the methods outlined by Adesemoye et al. (2014) and Berraf-Tebbal et al. (2020) [19,27]. Shoots with a diameter of 15 mm and approximately 20 cm in length were selected. They were then surface-disinfected with water containing 5% commercial powdered detergent for 10 min to remove dirt and insects, followed by treatment with 70% ethanol. Subsequently, the shoots were wounded on an intermediate internode using a scalpel.
For each strain, a 5 mm diameter mycelial disk taken from a 7-day-old colony growing on PDA was placed into the wound. Negative controls were inoculated with fresh, noncolonized PDA plugs. The point of inoculation was covered with parafilm to prevent desiccation. The detached branches were then well watered and maintained in a humid chamber under laboratory conditions. Three replicates per isolate were used, and an equal number of detached branches served as controls. One month after inoculation, the lengths of lesions produced by each strain were measured. Necrotic tissue from the margin of the lesions was collected at 30 days after inoculation, placed onto PDA, and molecularly identified to fulfill Koch’s postulates.
2.6. Pathogenicity on Persian Lime Plants from Certified Commercial Nursery and Virulence Tests
The pathogenicity of the 12 representative Lasiodiplodia isolates identified phylogenetically was tested on healthy 18-month-old Persian lime plants obtained from a certified commercial nursery. The inoculation procedure followed the protocol described by Bautista-Cruz et al. (2019). Each Persian lime plant was wounded 30 cm from the grafting area using a sterile scalpel, and a colonized PDA disk (5 mm diameter) from a 7-day-old culture was placed onto the wound site. The inoculation site was then covered with wet sterile cotton and sealed with parafilm to prevent desiccation. Five plants were inoculated with each isolate, while the control group received noncolonized PDA disks. Immediately after inoculation, each plant was enclosed in a plastic bag sprinkled with sterile distilled water for 72 h to maintain humidity. All plants were kept in a greenhouse under natural light and temperature conditions [28].
Virulence assessments were conducted 30 days after inoculation by removing the bark and measuring the lesion length in the wood using a digital caliper. The experiment was conducted twice to ensure accuracy and reliability. In both experiments, differences in virulence among Lasiodiplodia strains were analyzed with a one-way ANOVA and using the minimum significant difference (p ≤ 0.05) test with R v.3.5.1 statistical software.
To complete Koch’s postulates in both experiments, necrotic tissue from the margin of the lesions was sampled and plated onto PDA. The recovered fungal isolates were identified by amplifying and sequencing the tef1-α region. Since control plants did not display necrosis, cankers, or gummosis symptoms, and Lasiodiplodia spp. were not recovered from the mock-inoculated negative controls, it can be inferred that the plants were not latently infected with these pathogens prior to inoculation.
3. Results
3.1. Sample Collection, Isolation, and DNA Sequencing
Out of the 9229 Persian lime trees inspected across 230 hectares of Persian lime orchards in the state of Tabasco, Mexico, symptoms of gummosis, stem cankers, twig and branch dieback, fruit mummification, and decline (Figure 1) were detected in 4502 trees, representing a disease incidence of 48.78%. A total of 40 fungal isolates were obtained from diseased tissues collected from symptomatic Persian lime trees; cultural variability was observed in terms of the growth and color of each strain (Figure S1).
The 40 fungal strains obtained from Persian lime plants exhibiting cankers, as well as twig and branch dieback symptoms were identified at the genus level based on BLAST analysis of the ITS region, with 28 identified as Lasiodiplodia spp. additionally, their cultural characteristics of growth on PDA were also consistent with those of the Lasiodiplodia genus (Figure 2).
Figure 2.
Lasiodiplodia culture grown on PDA at 25 °C for 7 days. (A) IXBLT3, L. lignicola. (B) IXBLT4, L. pseudotheobromae. (C) IXBLT5, L. pseudotheobromae. (D) IXBLT6, L. pseudotheobromae. (E) IXBLT7, L. theobromae. (F) IXBLT9, L. theobromae. (G) IXBLT10, L. theobromae. (H) IXBLT12, L. pseudotheobromae. (I) IXBLT14, L. iraniensis. (J) IXBLT15, L. mexicanensis. (K) IXBLT16, L. iraniensis. (L) IXBLT18, L. pseudotheobromae.
The other 12 isolates belonged to the genera Diaporthe (3), Fusarium (8), and Pestalotiopsis (1) (Figure S1). Derived from the BLAST analysis of the ITS region, the sequences of tub2, tef1-α, and rpb2 were obtained for twelve representative Lasiodiplodia strains for subsequent phylogenetic analysis.
3.2. Phylogenetic Analyses
For the phylogenetic identification of Lasiodiplodia species, the combined datasets of four loci, ITS, tub2, tef1-α, and rpb2, comprising 81 Lasiodiplodia isolates, including the sequences of the 12 strains from this study, were analyzed alongside 69 sequences of 36 taxa with their extype specimens. Diplodia seriata (CBS 112555) was included and used as an outgroup taxon. The GTR+G+I model was selected for the concatenated loci.
The final alignment comprised 1684 characters, including gaps (ITS = 476, tef1-α = 324, tub2 = 394, rpb2 = 490). Both maximum likelihood (ML) and Bayesian inference (BI) analyses produced trees with similar topologies. The best-scoring ML tree with a final likelihood value of −6892.565692 is presented in Figure 3. The combined datasets for our twelve sequences resulted in the ubication of these strains in five clades, corresponding to the previously described Lasiodiplodia species, with moderate to high bootstrap supports and high posterior probabilities. Strains IXBLT14 and IXBLT16 clustered in the Lasiodiplodia iraniensis clade with strain CMM 3610, with a bootstrap support of 93% (ML)/1.00 posterior probability (PP); strains IXBLT7, IXBLT9, and IXBLT10 clustered in the Lasiodiplodia theobromae clade with L. theobromae CBS 164.96, CBS 111530, and MFLU22-0290, with an 84% ML/1.00 PP. The third clade comprised five strains: IXBLT4, IXBLT5, IXBLT6, IXBLT12, and IXBLT18, grouped with Lasiodiplodia pseudotheobromae CBS 116459, GXJG4.5, and MFLU22-0283 with 92% ML/1.00 PP. In the fourth clade, only IXBLT3 clustered with Lasiodiplodia lignicola (CBS 134112 and CGMCC 3.18061) with a 61% ML/0.96 PP; finally, IXBLT15 clustered in the Lasiodiplodia mexicanensis clade (LACAM1, AGQMy0015, and DSM 112342) with a 75% ML/0.90 PP. Furthermore, regarding the species L. citricola of Persian lime from Mexico, our findings demonstrated that strain UACH262, previously identified as L. citricola [28], is actually L. mexicanensis (Figure 3).
Figure 3.
Phylogenetic tree of Lasiodiplodia generated from ML analysis of the combined dataset of ITS, tef1-α, tub2, and rpb2. Bootstrap support values for ML ≥ 60% and Bayesian posterior probabilities (PPs) ≥ 0.90 are indicated above at the nodes. Ex−type strains are indicated in bold, and the species are delimited with colored blocks. The isolates collected in the present study are indicated in bold red letters with the nomenclature IXBLT followed by its strain number. The tree was rooted to Diplodia seriata (CBS 112555).
Therefore, in Persian lime trees, L. pseudotheobromae was the most frequently isolated species (41.6%), followed by L. theobromae (25%), L. iraniensis (16.6%), L. lignicola (8.3%), and L. mexicanensis (8.3%).
3.3. Pathogenicity and Virulence on Detached Branches and Plants from Certified Commercial Nursery of Persian Lime
Koch’s postulates for the Lasiodiplodia strains obtained from Persian lime tissue with dieback were completely corroborated by inoculating disks of PDA with mycelium on detached branches and certified plants. Thirty days after inoculation, all of the isolates belonging to the five Lasiodiplodia species identified in this study were pathogenic to Persian lime, with different degrees of severity, which was not the case for species belonging to other fungal genera (Figure S2). The wood from detached branches exhibited necrotic lesions that extended from both sides of the point of inoculation (Figure 4).
Figure 4.
Pathogenicity test on detached branches of Persian lime. (A–C) Negative controls inoculated with fresh, noncolonized PDA plugs. (D) IXBLT3 strain of L. lignicola. (E–G) IXBLT4, IXBLT5, IXBLT6 strains of L. pseudotheobromae. (H–J) IXBLT7, IXBLT9, IXBLT10 strains of L. theobromae. (K) IXBLT12 strain of L. pseudotheobromae. (L) IXBLT14 strain of L. iraniensis. (M) IXBLT15 strain of L. mexicanensis. (N) IXBLT16 strain of L. iraniensis. (O) IXBLT18 strain of L. pseudotheobromae. Red boxes show the detached branch before the bark was removed.
On Persian lime plants, the Lasiodiplodia strains induced the formation of gum exudations and necrosis in the tissue upward and downward from the point of inoculation (Figure 5). In both cases, the control plants showed no signs of the disease. Lasiodiplodia strains were consistently recovered from affected branches, while none were isolated from healthy control plants, thus satisfying Koch’s postulates.
Figure 5.
Pathogenicity test on 18-month-old Persian lime plants from certified nursery. (A,B) Negative controls inoculated with fresh, noncolonized PDA plugs. (C) IXBLT3 strain of L. lignicola. (D) IXBLT9 strain of L. theobromae. (E) IXBLT12 strain of L. pseudotheobromae. (F) IXBLT14 of L. iraniensis. (G) IXBLT15 of L. mexicanensis. Red boxes show the stem with the bark removed.
To determine the virulence, the lesion lengths caused by the most aggressive strain of each Lasiodiplodia species from two independent experiments on certified nursery Persian lime plants were averaged (Figure 6). There were significant differences in internal necrosis length produced by the different Lasiodiplodia species (p < 0.05). The longest mean lesions were produced by L. iraniensis, followed by L. pseudotheobromae and L. lignicola, which were the most virulent species. On the other hand, shorter mean lesions were induced by L. theobromae and L. mexicanensis, which were considered the least virulent species.
Figure 6.
Virulence of five Lasiodiplodia species associated with dieback of Persian lime as measured by mean internal lesion lengths (millimeters). Data are lesion sizes measured 30 days after inoculation with mycelium-colonized agar plugs inserted into wounded stem of 18-month-old Persian lime plants from certified nursery. Bars above columns are the standard errors of the means. Columns with the same letter do not differ significantly according to MSD test (p ≤ 0.05).
4. Discussion
The present study is the first to investigate the occurrence and pathogenicity of fungal species associated with twig and branch dieback, cankers, and decline of Persian lime trees (Citrus latifolia) in southern Mexico. Moreover, we elucidated the current status of Lasiodiplodia species causing disease in Mexico. Through multilocus molecular phylogenetic identification, pathogenicity, and virulence tests, five species were identified: L. pseudotheobromae, L. theobromae, L. iraniensis, L. lignicola, and L. mexicanensis. The latter two species are reported for the first time as causal agents of the disease in citrus.
The earliest reports characterizing the causal agents of citrus dieback date back to the 1900s. For orange (C. sinensis), Diplodia natalensis (family Botryosphaeriaceae) was identified as the causal agent of dieback, a disease known as “gummosis induction” [43]. In Robinson tangerine (C. reticulata), the causal agent of branch dieback was identified as L. theobromae [44]. However, the molecular characterization of fungi was not possible at that time. Currently, there are numerous reports describing the causal agents of dieback, cankers, gummosis, and decline in various citrus species [11,13,22,23,24,25,26,27,28].
In this study, 30 symptomatic branches of Persian lime were collected, and 40 fungal isolates were obtained. Based on their cultural growth characteristics on PDA and BLAST analysis of the ITS region, the isolates belong to the genera Diaporthe (7.5%), Fusarium (20%), Lasiodiplodia (70%), and Pestalotiopsis (2.5%), (Figure S1). It is not unusual to isolate other fungal genera from tissues exhibiting symptoms of twig and branch dieback, cankers, and fruit rot. In other studies, in addition to Lasiodiplodia, fungi from the genera Alternaria, Cladosporium, Colletotrichum, Cyphellophora, Curvularia, Diplodia, Dothiorella, Eutypella, Fusarium, Geotrichum, Neofusicoccum, Neoscytalidium, Nigrospora, and Phomopsis have been isolated [25,27,45,46,47]. The 70% of the isolates belonging to Lasiodiplodia is consistent with the findings of previous reports indicating that Lasiodiplodia is common in citrus, accounting for 55 to 80% of total isolates [13,19,22,27,46].
Multilocus molecular phylogenetic identification of the fungal isolates, based on combined ITS, tub2, tef1-α, and rpb2 sequence datasets, revealed that five Lasiodiplodia species were isolated from twig and branch dieback. These species included L. iraniensis, L. lignicola, L. mexicanensis, L. pseudotheobromae, and L. theobromae (Figure 3). Previously, Bautista-Cruz et al. (2019) reported six Lasiodiplodia species causing cankers and dieback in Persian lime: L. brasiliense, L. citricola, L. iraniensis, L. pseudotheobromae, L. subglobosa, and L. theobromae, three of which overlap with the species identified in the present study [28]. Nevertheless, L. lignicola and L. mexicanensis have not been reported as causing twig and branch dieback, cankers, fruit rot, gummosis, and tree decline in any citrus species, making this the first report of their association with Persian lime, representing a novel host–pathogen interaction.
L. pseudotheobromae was the most frequently isolated species (41.6%), which has been reported as causing twig and branch dieback, cankers, and gummosis in various citrus species: in China, on C. limon, C. reticulata, C. sinensis, and C. unshiu, being the second most frequent [22]; in Egypt, on C. sinensis [11]; in Iran on Citrus sp. [23]; in Mexico, on C. latifolia, being the most abundant species, consistent with our results [28]; in Pakistan, on C. reticulata [48]; in Suriname, from C. aurantium [31]; and, in Turkey, on C. limon [49].
L. theobromae was the second most abundant species isolated from C. latifolia (25%); this species has a cosmopolitan distribution, causing a variety of diseases on a wide range of host plants [50]. In citrus, it has been reported as causing twig and branch dieback, cankers, and gummosis: in Chile, on C. limon [51]; in China, on C. grandis [52], C. reticulata, and C. sinensis [22]; in Egypt, on C. reticulata [11]; in Iran, on C. aurantifolia [23]; in Malta, on C. sinensis [53]; in Mexico, on C. latifolia [28], C. limon, C. paradisi, and C. sinensis without pathogenicity testing [54]; in Oman, on C. aurantifolia, C. reticulata, and C. sinensis [26]; in the USA, isolated from Citrus sp. [46]; and, in Venezuela, on C. limon, C. paradisi, and C. sinensis [55].
L. iraniensis was the third most common species among the isolates examined in our study (16.6%). This species has previously been reported as a pathogen of Citrus sp. in Iran [23], on C. latifolia in Mexico [28], on C. reticulata in Pakistan [56], and recently on C. sinensis in the USA [13]. Therefore, research on this species is consistently growing.
In this work, L. lignicola and L. mexicanensis were the least commonly isolated species from symptomatic Persian lime tissues. L. lignicola was initially discovered as saprobic on the dead wood of an unidentified plant in Thailand, where it was named Auerswaldia lignicola [17]. However, phylogenetic studies reclassified it as Lasiodiplodia, forming a basal clade for other species [5], and it was also detected in a human keratitis case in a 32-year-old Indian male carpenter in India, in 2012, after trauma caused by a wooden piece [57]. Additionally, it was isolated as an endophytic fungus from the healthy tissue of Aquilaria crassna in Laos, suggesting a cosmopolitan role for L. lignicola [58]. Recently, L. lignicola was identified as causing canker and dieback diseases on Vangueria infausta subsp. rotundata and Berchemia discolor in lower eastern Kenya [59]. Therefore, this is the first report in the world of L. lignicola being associated with dieback symptoms in citrus species.
In the present study, we report for the first time that L. mexicanensis is a causal agent of canker and dieback in Persian lime. Additionally, we analyzed the current status of L. citricola as a causal agent of dieback in Persian lime in Mexico. Our findings clearly demonstrate that strain UACH262, previously identified as L. citricola [28], is actually L. mexicanensis (Figure 3). In this regard, the existence of hybrids between L. parva and L. citricola was previously hypothesized, previously suggested for Lasiodiplodia sp. LACAM1 obtained from Mangifera indica in Peru [60], therefore suggesting that strain UACH262 could be a hybrid, as it groups as a sister clade to L. citricola with high bootstrap/posterior probability (100/0.98). However, Lasiodiplodia sp. LACAM1 was recently identified as L. mexicanensis, a species closely related to L. parva and L. citricola, differing by a few nucleotides in the ITS, tub2, tef1-α, and rpb2 sequences, discarding the hypothesis of LACAM1 being a hybrid [61]. According to Cracraft’s phylogenetic species concept, this approach does not use data on reproductive isolation, such as hybridization, for the recognition of species taxa; in addition, biogeographic history is important [62]. Taking this principle into account, L. citricola was first isolated from Citrus sp. in Iran in 2010 [23], later from Juglans regia [63] and Prunus dulcis [64] in the USA, from Acacia spp. [65] and Persea americana [66] in Italy, and recently from Eriobotrya japonica, Malus domestica, Vitis vinifera, and Juglans regia in China [16]. Therefore, phylogenetic and biogeographic data support L. mexicanensis as a species distinct from L. citricola.
At the nucleotide level, strain UACH262 has the following similarities with the ITS, tub2, and tef1-α sequences: 100% (533/533), 100% (429/429), and 99.78% (444/445) with the ex-type of L. mexicanensis, and 99.79% (476/477), 99.48% (379/381), and 99.02% (302/305) with the extype of L. citricola, respectively. The rpb2 sequences are not available for the UACH262 strain.
On the other hand, in the state of Morelos, Mexico, L. citricola was described as a causal agent of dieback in C. latifolia [67], but, in that study, only the ITS region (KY271187) was used, presenting 100% (540/540) coverage and identity with the extype of L. mexicanensis and 99.79% (476/477) coverage and identity with the extype of L. citricola, respectively. Currently, for the accurate identification of Lasiodiplodia species, the combination of four loci, ITS, tef1-α, tub2, and rpb2, is necessary for reliable resolution [15]. Therefore, it can be concluded that L. citricola has not yet been described as associated with canker and dieback in Persian lime (C. latifolia) at this time.
The results of pathogenicity testing showed that the isolates of L. iraniensis were the most virulent, causing the formation of gum exudates and necrosis in the tissue (Figure 5F). These findings are consistent with those of Bautista-Cruz et al. (2019), where L. iraniensis exhibited the highest virulence along with L. subglobosa [28], and Piattino et al. (2024), where L. iraniensis isolates produced the largest necrotic areas compared to Diaporthe spp. [13]. L. pseudotheobromae was the second most virulent in Persian lime (Figure 5E), agreeing with results reported by Bautista-Cruz et al. (2019) [22] and Xiao et al. (2021) [28], where it was one of the most aggressive species on citrus shoots. L. lignicola was the third most aggressive species (Figure 5C), with lesion lengths of 23 ± 3.8 mm (Figure 6). This species has typically been characterized as a saprophyte [17] or endophyte [58]. However, pathogenicity tests on Berchemia discolor and Olea europaea showed lesion lengths of 22.6 ± 3.0 mm and 20.1 ± 2.6 mm, respectively [59], which align with the findings of the present study. Finally, L. mexicanensis and L. theobromae were the least virulent species (Figure 6), consistent with Bautista-Cruz et al. (2019), where strain UACH262 and L. theobromae were the least virulent [28], and with El-Ganainy et al. (2022), where L. theobromae showed less severity than L. pseudotheobromae and L. laeliocattleyae on Citrus sp. [11], but contrasting Espargham et al. (2020) [24], where L. theobromae was more virulent on C. aurantifolia shoots than other fungal species.
5. Conclusions
The results presented in this study demonstrate that in southern Mexico, at least five species of the genus Lasiodiplodia are responsible for dieback in Persian lime. The identified species were L. pseudotheobromae, L. theobromae, L. iraniensis, L. lignicola, and L. mexicanensis. The most abundant species was L. pseudotheobromae, which was also the most virulent along with L. iraniensis. On the other hand, multilocus phylogenetic analyses allowed the identification for the first time that the species L. lignicola and L. mexicanensis are also responsible for dieback in Persian lime. Additionally, it was determined that the strain previously classified as L. citricola actually corresponds to L. mexicanensis, confirming that this species causes dieback in Persian lime.
Supplementary Materials
The following supporting information can be downloaded at: https://www.mdpi.com/article/10.3390/jof10070484/s1, Figure S1: Culture grown on PDA at 25 °C for 7 days of fungal isolates from Persian lime; Figure S2: Diaporthe, Fusarium, and Pestalotiopsis inoculation on detached branches of Persian lime.
Author Contributions
Conceptualization, R.S.-M., H.E.-M. and F.R.F.-d.l.R.; methodology, R.S.-M. and L.M.-O.; investigation, R.S.-M., H.E.-M., S.P.F.-P., G.R.-A. and C.M.-H.; data curation R.S.-M., L.M.-O. and H.E.-M.; writing—original draft preparation, R.S.-M. and F.R.F.-d.l.R.; writing—review and editing, R.S.-M., H.E.-M., S.P.F.-P., G.R.-A., C.M.-H. and F.R.F.-d.l.R.; funding acquisition, R.S.-M., H.E.-M. and F.R.F.-d.l.R. All authors have read and agreed to the published version of the manuscript.
Funding
This research was funded by Consejo Nacional de Humanidades, Ciencias y Tecnologías (CONAHCYT) through the project “Fortalecimiento del equipo e infraestructura para el estudio y control de las principales enfermedades de cítricos para incidir en el bienestar social de la zona citrícola de Veracruz” (Project No. 322068).
Institutional Review Board Statement
Not applicable.
Informed Consent Statement
Not applicable.
Data Availability Statement
The data generated are available upon a reasonable requisition.
Acknowledgments
L.M.-O. is grateful for the scholarship awarded by Consejo Nacional de Humanidades, Ciencias y Tecnologías (CONAHCYT) for the completion of their undergraduate thesis. The authors acknowledge anonymous reviewers for their invaluable comments on this manuscript.
Conflicts of Interest
The authors declare no conflicts of interest.
References
- FAO (Food and Agriculture Organization). Online Statistical Database. FAOSTAT. 2022. Available online: https://www.fao.org/faostat/es/#data/QCL (accessed on 15 April 2024).
- SIAP (Servicio de Información Agroalimentaria y Pesquera). Anuario Estadístico de la Producción Agrícola. 2022. Available online: https://www.gob.mx/siap (accessed on 15 April 2024).
- Talhinhas, P.; Baroncelli, R. Colletotrichum species and complexes: Geographic distribution, host range and conservation status. Fungal Divers 2021, 110, 109–198. [Google Scholar] [CrossRef]
- Gaikwad, P.N.; Sharma, V.; Singh, J.; Sidhu, G.S.; Singh, H.; Omar, A. Biotechnological advancements in Phytophthora disease diagnosis, interaction and management in citrus. Sci. Hortic. 2023, 310, 111739. [Google Scholar] [CrossRef]
- Phillips, A.J.L.; Alves, A.; Abdollahzadeh, J.; Slippers, B.; Wingfield, M.J.; Groenewald, J.Z.; Crous, P.W. The Botryosphaeriaceae: Genera and species known from culture. Stud. Mycol. 2013, 76, 51–167. [Google Scholar] [CrossRef] [PubMed]
- Tarnowski, T.; Palmateer, A.J.; Maguire, I.; Crane, J.H. Florida Plant Disease Management Guide: ‘Tahiti’ Lime (Citrus latifolia), 1st ed.; University of Florida, IFAS Extension: Gainesville, FL, USA, 2013; PP24/VH049. [Google Scholar] [CrossRef]
- Sáenz-Pérez, C.A.; Osorio-Hernández, E.; Estrada-Drouaillet, B.; Poot-Poot, W.A.; Delgado-Martínez, A.; Rodríguez-Herrera, R. Main diseases in citrus. Rev. Mex. Cienc. Agríc. 2019, 10, 1653–1665. [Google Scholar] [CrossRef]
- Phillips, A.J.L.; Hyde, K.D.; Alves, A.; Liu, J.K. Families in Botryosphaeriales: A phylogenetic, morphological, and evolutionary perspective. Fungal Divers. 2019, 94, 1–22. [Google Scholar] [CrossRef]
- Slippers, B.; Wingfield, M.J. Botryosphaeriaceae as endophytes and latent pathogens of woody plants: Diversity, ecology and impact. Fungal Biol. Rev. 2007, 21, 90–106. [Google Scholar] [CrossRef]
- Zhang, W.; Groenewald, J.Z.; Lombard, L.; Schumacher, R.K.; Phillips, A.J.L.; Crous, P.W. Evaluating species in Botryosphaeriales. Persoonia 2021, 46, 63–115. [Google Scholar] [CrossRef] [PubMed]
- El-Ganainy, S.M.; Ismail, A.M.; Iqbal, Z.; Elshewy, E.S.; Alhudaib, K.A.; Almaghasla, M.I.; Magistà, D. Diversity among Lasiodiplodia Species Causing Dieback, Root Rot and Leaf Spot on Fruit Trees in Egypt, and a Description of Lasiodiplodia newvalleyensis sp. nov. J. Fungi 2022, 8, 1203. [Google Scholar] [CrossRef] [PubMed]
- Mondragón-Flores, A.; Rodríguez-Alvarado, G.; Gómez-Dorantes, N.; Guerra-Santos, J.J.; Fernández-Pavía, S.P. Botryosphaeriaceae: A complex, diverse and cosmopolitan family of fungi. Rev. Mex. Cienc. Agríc. 2021, 12, 643–654. [Google Scholar] [CrossRef]
- Piattino, V.; Aiello, D.; Dardani, G.; Martino, I.; Flores, M.; Aćimović, S.G.; Spadaro, D.; Polizzi, G.; Guarnaccia, V. Lasiodiplodia iraniensis and Diaporthe spp. are Associated with Twig Dieback and Fruit Stem-End Rot of Sweet Orange, Citrus sinensis, in Florida. Horticulturae 2024, 10, 406. [Google Scholar] [CrossRef]
- Leyva-Mir, S.G.; Bautista-Cruz, M.A.; Almaguer-Vargas, G.; Colinas-León, M.T.; Tovar-Pedraza, J.M.; Camacho-Tapia, M. Effectiveness of fungicides and Trichorderma spp. for the control of Lasiodiplodia spp. in ‘Persian’ lemon orchards in Veracruz. Rev. Mex. Cienc. Agríc. 2021, 12, 345–353. [Google Scholar] [CrossRef]
- Rathnayaka, A.R.; Chethana, K.W.T.; Manawasinghe, I.S.; Wijesinghe, S.N.; de Silva, N.I.; Tennakoon, D.S.; Phillips, A.J.L.; Liu, J.K.; Jones, E.B.G.; Wang, Y.; et al. Lasiodiplodia: Generic revision by providing molecular markers, geographical distribution and haplotype diversity. Mycosphere 2023, 14, 1254–1339. [Google Scholar] [CrossRef]
- Wang, Y.; Song, X.; Xie, S.; Geng, Y.; Xu, C.; Yin, X.; Zang, R.; Guo, L.; Zhang, M.; Guo, Y. Diversity of Lasiodiplodia Species Associated with Canker and Dieback in Fruit Trees in the Henan and Shandong Provinces of China. Plant Dis. 2024, 108, 563–575. [Google Scholar] [CrossRef]
- Liu, J.K.; Phookamsak, R.; Doilom, M.; Wikee, S.; Li, Y.M.; Ariyawansha, H.; Boonmee, S.; Chomnunti, P.D.D.Q.; Bhat, J.D.; Romero, A.I.; et al. Towards a natural classification of Botryosphaeriales. Fungal Divers. 2012, 57, 149–210. [Google Scholar] [CrossRef]
- Slippers, B.; Roux, J.; Wingfield, M.J.; van der Walt, F.J.; Jami, F.; Mehl, J.W.; Marais, G.J. Confronting the constraints of morphological taxonomy in the Botryosphaeriales. Persoonia 2014, 33, 155–168. [Google Scholar] [CrossRef] [PubMed]
- Berraf-TebbalI, A.; Eddine-Mahamedi, A.; Aigoun-Mouhous, W.; Spetik, M.; Cechova, J.; PokludaI, R.; Barane, M.; Eichmeier, A.; Alves, A. Lasiodiplodia mitidjana sp. nov. and other Botryosphaeriaceae species causing branch canker and dieback of Citrus sinensis in Algeria. PLoS ONE 2020, 15, e0232448. [Google Scholar] [CrossRef]
- Freire, F.C.O.; Cardoso, J.E.; Viana, F.M.P.; Martins, M.V.V. Status of Lasiodiplodia theobromae as a plant pathogen in Brazil. Essentia 2011, 12, 53–71. [Google Scholar]
- Coutinho, I.B.L.; Freire, F.C.O.; Lima, C.S.; Lima, J.S.; Gonçalves, F.J.T.; Machado, A.R.; Silva, A.M.S.; Cardoso, J.E. Diversity of genus Lasiodiplodia associated with perennialtropical fruit plants in northeastern Brazil. Plant Path. 2017, 66, 90–104. [Google Scholar] [CrossRef]
- Xiao, X.E.; Wang, W.; Crous, P.W.; Wang, H.K.; Jiao, C.; Huang, F.; Pu, Z.X.; Zhu, Z.R.; Li, H.Y. Species of Botryosphaeriaceae associated with citrus branch diseases in China. Persoonia 2021, 47, 106–135. [Google Scholar] [CrossRef]
- Abdollahzadeh, J.; Javadi, A.; Mohammadi-Goltapeh, E.; Zare, R.; Phillips, A.J.L. Phylogeny and morphology of four new species of Lasiodiplodia from Iran. Persoonia 2010, 25, 1–10. [Google Scholar] [CrossRef]
- Espargham, N.; Mohammadi, H.; Gramaje, D. A Survey of Trunk Disease Pathogens within Citrus Trees in Iran. Plants 2020, 9, 754. [Google Scholar] [CrossRef] [PubMed]
- Polanco-Florián, L.G.; Alvarado-Gómez, O.G.; Pérez-González, O.; González-Garza, R.; Olivares-Sáenz, E. Fungi associated with the regressive death of citrus fruits in Nuevo Leon and Tamaulipas, Mexico. Rev. Mex. Cienc. Agríc. 2019, 10, 757–764. [Google Scholar] [CrossRef]
- Al-Sadi, A.M.; Al-Weheibi, A.N.; Al-Shariqi, R.M.; Al-Hammadi, M.S.; Al-Hosni, I.A.; Al-Mahmooli, I.H.; Al-Ghaithi, A.G. Population genetic analysis reveals diversity in Lasiodiplodia species infecting date palm, Citrus, and mango in Oman and the UAE. Plant Dis. 2013, 97, 1363–1369. [Google Scholar] [CrossRef] [PubMed]
- Adesemoye, A.O.; Mayorquin, J.S.; Wang, D.H.; Twizeyimana, M.; Lynch, S.C.; Eskalen, A. Identification of species of Botryosphaeriaceae causing bot gummosis in citrus in California. Plant Dis. 2014, 98, 55–61. [Google Scholar] [CrossRef] [PubMed]
- Bautista-Cruz, M.A.; Almaguer-Vargas, G.; Leyva-Mir, G.; Colinas-León, M.T.; Correia, K.; Camacho-Tapia, M. Phylogeny, distribution, and pathogenicity of Lasiodiplodia species associated with cankers and dieback symptoms of persian lime in Mexico. Plant Dis. 2019, 103, 1156–1165. [Google Scholar] [CrossRef] [PubMed]
- Santillán-Mendoza, R.; Fernández-Pavía, S.P.; O’Donnell, K.; Ploetz, R.C.; Ortega-Arreola, R.; Vázquez-Marrufo, G.; Benítez-Malvido, J.; Montero-Castro, J.C.; Soto-Plancarte, A.; Rodríguez-Alvarado, G. A novel disease of big-leaf mahogany caused by two Fusarium species in Mexico. Plant Dis. 2018, 102, 1965–1972. [Google Scholar] [CrossRef] [PubMed]
- White, T.J.; Bruns, T.; Lee, S.; Taylor, J. Amplification and direct sequencing of fungal ribosomal rna genes for phylogenetics. PCR Protoc. A Guide Methods Appl. 1990, 18, 315–322. [Google Scholar]
- Glass, N.L.; Donaldson, G.C. Development of primer sets designed for use with the PCR to amplify conserved genes from filamentous ascomycetes. Appl. Environ. Microbiol. 1995, 61, 1323–1330. [Google Scholar] [CrossRef]
- Alves, A.; Crous, P.W.; Correia, A.; Phillips, A.J.L. Morphological and molecular data reveal cryptic species in Lasiodiplodia theobromae. Fungal Divers. 2008, 28, 1–13. [Google Scholar]
- Liu, Y.J.; Whelen, S.; Hall, B.D. Phylogenetic relationships among ascomycetes: Evidence from an RNA polymerse II subunit. Mol. Biol. Evol. 1999, 16, 1799–1808. [Google Scholar] [CrossRef]
- Staden, R.; Beal, K.F.; Bonfield, J.K. The Staden Package. In Bioinformatics Methods and Protocols; Misener, S., Krawetz, S.A., Eds.; Humana Press: Totowa, NJ, USA, 1998; Volume 132, pp. 115–130. [Google Scholar] [CrossRef]
- Katoh, K.; Rozewicki, J.; Yamada, K.D. MAFFT online service: Multiple sequence alignment, interactive sequence choice and visualization. Brief. Bioinform. 2019, 20, 1160–1166. [Google Scholar] [CrossRef] [PubMed]
- Tamura, K.; Stecher, G.; Kumar, S. MEGA11: Molecular Evolutionary Genetics Analysis Version 11. Mol. Biol. Evol. 2021, 38, 3022–3027. [Google Scholar] [CrossRef]
- Vaidya, G.; Lohman, D.J.; Meier, R. SequenceMatrix: Concatenation software for the fast assembly of multi-gene datasets with character set and codon information. Cladistics 2011, 27, 171–180. [Google Scholar] [CrossRef] [PubMed]
- Darriba, D.; Posada, D.; Kozlov, A.M.; Stamatakis, A.; Morel, B.; Flouri, T. ModelTest-NG: A New and Scalable Tool for the Selection of DNA and Protein Evolutionary Models. Mol. Biol. Evol. 2020, 37, 291–294. [Google Scholar] [CrossRef] [PubMed]
- Stamatakis, A. RAxML version 8: A tool for phylogenetic analysis and post-analysis of large phylogenies. Bioinformatics 2014, 30, 1312–1313. [Google Scholar] [CrossRef] [PubMed]
- Ronquist, F.; Teslenko, M.; van der Mark, P.; Ayres, D.L.; Darling, A.; Höhna, S.; Larget, B.; Liu, L.; Suchard, M.A.; Huelsenbeck, J.P. MrBayes 3.2: Efficient Bayesian phylogenetic inference and model choice across a large model space. Syst. Biol. 2012, 61, 539–542. [Google Scholar] [CrossRef] [PubMed]
- Miller, M.A.; Pfeiffer, W.; Schwartz, T. Creating the CIPRES Science Gateway for inference of large phylogenetic trees. In Gateway Computing Environments Workshop; IEEE: New Orleans, LA, USA, 2010; pp. 1–8. [Google Scholar] [CrossRef]
- Rambaut, A. FigTree v1.4.0; University of Oxford: Oxford, UK, 2012; Available online: http://tree.bio.ed.ac.uk/software/figtree (accessed on 10 June 2024).
- Fawcett, H.S.; Burger, O.F. A gum-inducing Diplodia of peach and orange. Mycologia 1911, 3, 151–153. [Google Scholar] [CrossRef]
- Feder, W.A.; Hutchins, P.C. Twig gumming and dieback of the ‘Robinson’ tangerine. Plant Dis. Rep. 1966, 50, 429–430. [Google Scholar]
- Mayorquin, J.S.; Wang, D.H.; Twizeyimana, M.; Eskalen, A. Identification, distribution, and pathogenicity of Diatrypaceae and Botryosphaeriaceae associated with citrus branch canker in the southern California desert. Plant Dis. 2016, 100, 2402–2413. [Google Scholar] [CrossRef]
- Davis, R.M.; Farrald, C.J.; Davila, D. Botryodiplodia trunk lesions in Texas citrus. Plant Dis. 1987, 71, 848–849. [Google Scholar] [CrossRef]
- Chen, J.; Zhu, Z.; Fu, Y.; Cheng, J.; Xie, J.; Lin, Y. Identification of Lasiodiplodia pseudotheobromae Causing Fruit Rot of Citrus in China. Plants 2021, 10, 202. [Google Scholar] [CrossRef]
- Ahmed, M.Z.; Shafique, M.S.; Anwaar, H.A.; Sarfraz, S.; Tufail, M.R.; Fayyaz, A.; Muntaha, S.; Haque, K.; Ghuffar, S.; Amrao, L. First report of Lasiodiplodia pseudotheobromae causing trunk cankers in Citrus reticulata in Pakistan. Plant Dis. 2020, 104, 2522. [Google Scholar] [CrossRef]
- Awan, Q.N.; Akgul, D.S.; Unal, G. First report of Lasiodiplodia pseudotheobromae causing postharvest fruit rot of lemon in Turkey. Plant Dis. 2016, 100, 2327. [Google Scholar] [CrossRef]
- Mohali, S.; Burgess, T.; Wingfield, M.J. Diversity and host association of the tropical tree endophyte Lasiodiplodia theobromae revealed using simple sequence repeat markers. For. Pathol. 2005, 35, 385–396. [Google Scholar] [CrossRef]
- Guajardo, J.; Riquelme, N.; Tapia, L.; Larach, A.; Torres, C.; Camps, R.; Besoain., X. First Report of Lasiodiplodia theobromae Causing Bot Gummosis in Citrus limon in Chile. Plant Dis. 2018, 102, 818. [Google Scholar] [CrossRef]
- Luo, M.; Dong, Z.Y.; Bin, S.Y.; Lin, J.T. First Report of Fruit Rot Disease on Pomelo Caused by Lasiodiplodia theobromae in China. Plan Dis. 2011, 95, 1190. [Google Scholar] [CrossRef]
- Pereira-Bezerra, J.D.; Crous, P.W.; Aiello, D.; Gullino, M.L.; Polizzi, G.; Guarnaccia, V. Genetic Diversity and Pathogenicity of Botryosphaeriaceae Species Associated with Symptomatic Citrus Plants in Europe. Plants 2021, 10, 492. [Google Scholar] [CrossRef]
- Flores-Hernández, H.; Flores-Gracia, J.; Varela-Fuentes, S.E.; Pérez-Rodríguez, A.; Azuara-Domínguez, A.; Monteon-Ojeda, A. Report of Lasiodiplodia theobromae (Pat.) Griffon and Maubl. in citrus trees in Tamaulipas. Rev. Mex. Cienc. Agríc. 2021, 12, 499–511. [Google Scholar] [CrossRef]
- Ferrari, F.D.; Ochoa, C.F.M.; Subero, M.L.J. Dieback and gummosis induced by Lasiodiplodia theobromae (Pat.) Griffon and Maubl. on three citrus tree species. An. Bot. Agric. 1996, 3, 46–49. [Google Scholar]
- Fayyaz, A.; Bonello, P.; Tufail, M.R.; Amrao, L.; Habib, A.; Gai, Y.; Sahi, S.T. First Report of Citrus Withertip (Tip Dieback), a Disease Complex Caused by Colletotrichum siamense and Lasiodiplodia iraniensis, on Citrus reticulata cv. Kinnow in Punjab, Pakistan. Plant Dis. 2018, 102, 2659. [Google Scholar] [CrossRef]
- Ruban, V.V.; Kaliamurthy, J.; Dineshkumar, M.; Jesudasan, C.A.N.; Geraldine, P.; Thomas, P.A. Keratitis Due to the Wood Saprobic Ascomycete, Auerswaldia lignicola (Family Botryosphaeriaceae), in a Carpenter in India. Mycopathologia 2013, 176, 463–466. [Google Scholar] [CrossRef] [PubMed]
- Wang, Y.; Lin, S.; Zhao, L.; Sun, X.; He, W.; Zhang, Y.; Dai, Y.C. Lasiodiplodia spp. associated with Aquilaria crassna in Laos. Mycol. Prog. 2019, 18, 683–701. [Google Scholar] [CrossRef]
- Karani, S.; Njuguna, J.; Runo, S.; Muchugi, A.; Machua, J.; Mwaniki, P. Molecular and morphological identification of fungi causing canker and dieback diseases on Vangueria infausta (Burch) subsp. rotundata (Robyns) and Berchemia discolor (Klotzsch) Hemsl in lower Eastern Kenya. Afr. J. Biotechnol. 2022, 21, 6–15. [Google Scholar] [CrossRef]
- Rodríguez-Gálvez, E.; Guerrero, P.; Barradas, C.; Crous, P.W.; Alves, A. Phylogeny and pathogenicity of Lasiodiplodia species associated with dieback of mango in Peru. Fungal Biol. 2017, 121, 452–465. [Google Scholar] [CrossRef] [PubMed]
- Douanla-Meli, C.; Scharnhorst, A. Palm Foliage as Pathways of Pathogenic Botryosphaeriaceae Fungi and Host of New Lasiodiplodia Species from Mexico. Pathogens 2021, 10, 1297. [Google Scholar] [CrossRef]
- Cracraft, J. Species Concepts and Speciation Analysis. In Current Ornithology; Johnston, R.F., Ed.; Springer: New York, NY, USA, 1983; Volume 1, pp. 159–187. [Google Scholar] [CrossRef]
- Chen, S.F.; Fichtner, E.; Morgan, D.P.; Michailides, T.J. First Report of Lasiodiplodia citricola and Neoscytalidium dimidiatum Causing Death of Graft Union of English Walnut in California. Plant Dis. 2013, 97, 993. [Google Scholar] [CrossRef]
- Chen, S.F.; Morgan, D.P.; Hasey, J.K.; Michailides, T.J. First report of Lasiodiplodia citricola associated with stem canker of peach in California, USA. J. Plant Pathol. 2013, 95, 659. [Google Scholar] [CrossRef]
- Costanzo, M.B.; Gusella, G.; Fiorenza, A.; Leonardi, G.R.; Aiello, D.; Polizzi, G. Lasiodiplodia citricola, a new causal agent of Acacia spp. dieback. New Dis. Rep. 2022, 45, e12094. [Google Scholar] [CrossRef]
- Fiorenza, A.; Gusella, G.; Vecchio, L.; Aiello, D.; Polizzi, G. Diversity of Botryosphaeriaceae species associated with canker and dieback of avocado (Persea americana) in Italy. Phytopathol. Medit. 2023, 62, 47–63. [Google Scholar] [CrossRef]
- Valle-de la Paz, M.; Guillén-Sánchez, D.; Gijón-Hernández, A.R.; Alía-Tecal, I.; López-Martínez, V.; Juárez-López, P.; Martínez-Fernández, E.; Hernández-Arenas, M.; Ariza-Flores, R. Species of Lasiodiplodia in lima ‘Persa’ (Citrus latifolia Tanaka) in Morelos, México. Rev. Bio Cienc. 2019, 6, e595. [Google Scholar] [CrossRef]
Disclaimer/Publisher’s Note: The statements, opinions and data contained in all publications are solely those of the individual author(s) and contributor(s) and not of MDPI and/or the editor(s). MDPI and/or the editor(s) disclaim responsibility for any injury to people or property resulting from any ideas, methods, instructions or products referred to in the content. |
© 2024 by the authors. Licensee MDPI, Basel, Switzerland. This article is an open access article distributed under the terms and conditions of the Creative Commons Attribution (CC BY) license (https://creativecommons.org/licenses/by/4.0/).